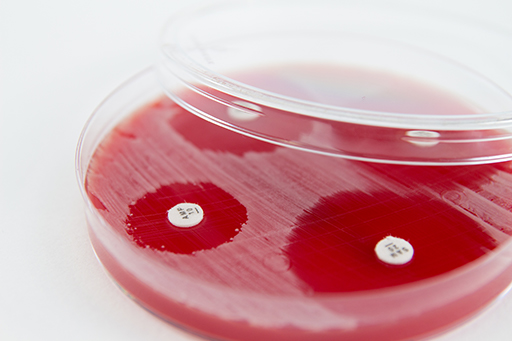
Described image

4.3 Data on resistant bacteria
Data on resistant bacteria, both pathogenic and commensal, are extremely important for understanding the impact on public health and for an effective response to the problem. Monitoring and surveillance systems for resistant bacteria need to be in place to generate these data. Information about changes in resistant bacteria over time, such as changes in prevalence, is necessary to understand the effect of any interventions. The FAO is coordinating the future harmonisation of AMR monitoring and surveillance data in animals: as such, the InFARM system [Tip: hold Ctrl and click a link to open it in a new tab. (Hide tip)] is the FAO’s global information platform to assist countries in collecting, analysing and utilising AMR data from the food and agriculture sectors.
Data collection on resistant bacteria must include both sick and healthy animals. As you have learnt earlier in the course, resistant commensal bacteria do not cause clinical signs in animals, but some of them may be transmitted to humans where they could cause disease. Monitoring and surveillance systems are needed to assess the new emergence of resistance in animals and the effect of interventions.

Data on resistant bacteria can be obtained through a variety of methods, depending on the purpose of the investigation. For example,
Samples for both types of tests could be taken from a range of sources, such as sick and healthy animals, carcasses, other animal products, animal feed and the environment. In the broiler and aquaculture system shown in Figure 11, we could investigate potential transmission of resistant bacteria in the system by testing for non-typhoidal Salmonella spp. in broiler faeces, water from the aquaculture pond and carcasses of broilers at the abattoir. The results from each part of the system could be compared to each other as well as to data obtained from the local hospital.
The WHO has set up the ‘tricycle protocol’ as a One Health approach to global AMR surveillance, particularly in countries that lack sophisticated surveillance mechanisms. This monitors a single indicator of AMR across the human, food chain and environmental sectors, the project name being derived from those three sectors. It takes a single indicator: the prevalence of E. coli bacteria that produce extended spectrum beta-lactamases (ESBLs) and that are therefore resistant to beta-lactam-based antibiotics such as penicillins.
The tricycle protocol will be expanded upon in later courses.
4.2 AMU data

